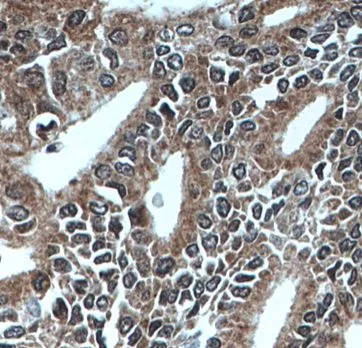
MEST antibody - image 1

MEST antibody
CAT:
710-FNab05132
Size:
100 µg
Price:
Ask
- Availability: 24/48H Stock Items & 2 to 6 Weeks non Stock Items.
- Dry Ice Shipment: No

MEST antibody
Synonyms:
Mesoderm-specific transcript homolog protein|Paternally-expressed gene 1 protein|MEST|PEG1Gene ID:
4232UniProt:
Q5EB52Host:
RabbitReactivity:
Human, Mouse, RatImmunogen:
mesoderm specific transcript homolog(Mouse)Target:
MESTClonality:
PolyclonalIsotype:
IgGApplications:
ELISA, WB, IHC, IPField of Research:
MetabolismPurification:
Immunogen affinity purifiedDilution:
WB: 1:500-1:2000; IP: 1:200-1:1000; IHC: 1:20-1:200Purity:
≥95% as determined by SDS-PAGEForm:
LiquidMolecular Weight:
34 kDaStorage Conditions:
PBS with 0.02% sodium azide and 50% glycerol pH 7.3, -20°C for 12 months(Avoid repeated freeze / thaw cycles.)CAS Number:
9007-83-4